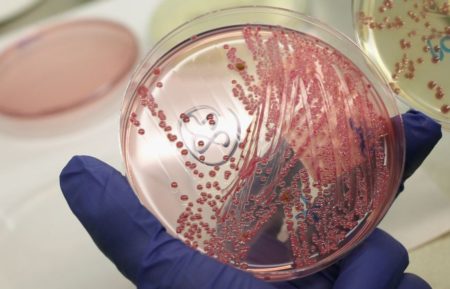
image

Чтобы эффективно бороться с комарами, следует понимать их особенности жизнедеятельности и способы ведения охоты. Подробные знания, чего боятся комары, помогли разработать максимально эффективные химические препараты, а также научиться применять домашние средства.
Особенности жизнедеятельности комаров
Природа наделила кровососущих насекомых отменным обонянием. Именно с его помощью они улавливают запах жертвы на очень больших расстояниях.
Рацион комаров различен. Ученые доказали тот факт, что кровь пьют самки. Самцы по образу питания относятся к вегетарианцам и даже не имеют ротового аппарата, при помощи которого можно было бы производить укус.
Прежде чем говорить, какой запах отпугивает комаров, нужно разобраться, что их притягивает и по какому признаку самка находит свою жертву.
- Повышенная концентрация углекислого газа. Он выделяется человеком во время дыхания, поэтому насекомым легко определить местоположение своей жертвы.
- Пот. Особенно актуально для душных летних ночей.
- Тепло. Температура тела становится еще одним явным индикатором для комариных самок.
Задача человека в домашних условиях подобрать вещество, которое будет пахнуть сильнее его естественных запахов. В этом случае комар не сможет подобраться к жертве. При использовании очень сильных ароматов насекомое совсем теряет пространственные ориентиры и переходит в хаотичный полет.
Самые сильные запахи, которые отпугивают комаров
Запахи, отпугивающие комаров, имеют как природный характер, так и химический. Все они обеспечивают надежную защиту. Их многообразие позволяет использовать ароматерапию в борьбе с насекомыми дома или на улице. Комары очень боятся растений с сильным запахом. Часто их аромат бывает очень приятным для людей, но невыносимым для насекомых. Это позволяет получить дополнительное преимущество в использовании природных способов защиты. Растения для отпугивания комаров можно высаживать на приусадебном участке, раскладывать букеты, гербарии в доме или квартире.
- Бузина. Является одним из тех растений, чей сок и запах не любят кровопийцы. При выборе места пикника можно обосноваться поближе к этому многолетнему кусту. Чтобы обеспечить защиту в домашних условиях, потребуется измельчить листья бузины и разложить на тарелочки. Посуду поставить на подоконники. Насекомые не смогут проникнуть в дом пока сила запаха не уменьшится. Менять материал следует по мере высыхания.
- Черемуха. Этот запах ассоциируется с наступлением весны. Приятный и нежный аромат растения отлично отпугнет комаров. Можно посадить деревья на участке вблизи дома или наломать пышные букеты веток.
- Хвойные. Вдыхать ароматы хвои очень полезно человеку, поэтому такой способ защиты от комаров имеет двойное действие. Насекомые не переносят запах ели, сосны, можжевельника и пихты. Используется как сама хвоя, так и шишки. В Сибири из еловых шишек научились изготавливать самодельные отпугиватели.
- Цитронелла и герань. Эти два растения следует выделить в отдельную группу. Так как именно их экстракты или эфирные масла используются для приготовления синтетических репеллентов от комаров. В небольших концентрациях растения используют, чтобы комары не кусали ребенка. Достаточно нанести по несколько капель эфирного масла на капюшон коляски, чтобы обезопасить малыша на время прогулки.
- Цитрусы. Также комаров отгоняет запах лимонов, лайма, грейпфрута или апельсина. Даже можно сделать самостоятельно специальные отпугиватели, которые легко смастерить из лимона и гвоздики. Для защиты будет достаточно расставить блюдца с такими устройствами по периметру стола или в комнате.
- Карболовая кислота. Данное средство известно, как эффективный антисептик и способно оказывать бактерицидное действие. Этот ингредиент также используют в борьбе с кровососами. Достаточно просто окропить изголовье кровати и стены или протереть поверхности мягкой тряпкой, смоченной в растворе.
- Рыбий жир. Его не любят не только дети, но и кровососущие насекомые. Если обмазать открытые участки тела этим ингредиентом, то насекомые не смогут укусить. Таким способом обеспечивают спасение от укусов комаров и многих других летающих насекомых.
- Дым. Самый простой способ отогнать кровососов от человека во время пикника – это развести костер. Дым полностью лишит насекомых возможности ориентироваться в пространстве. Для эффекта можно подкинуть в костер сухой травы. Она обеспечит большое количество дыма. Также стоит вспомнить и тот факт, что комары не переносят запаха хвойных, и добавить в огонь еловые ветки или шишки.
- Соевый соус. Для человека он практически не обладает запахом, но способен обеспечить спасение от укусов на протяжении всей ночи. Для этого нужно просто поставить на прикроватную тумбочку небольшую миску с жидкостью.

Также кровососущие насекомые боятся запахов валерианы, мяты, мелиссы, корицы, березового дегтя, чабреца и чеснока. Для защиты их можно раскладывать в комнате, готовить настои или просо наносить приготовленные отвары на тело и одежду.
Как бороться с комарами при помощи запахов
На способности резких запахов отпугивать кровососов основаны многие современные препараты. Но еще задолго до появления химии, такую особенность использовали для борьбы с насекомыми народными средствами. Надежные и эффективные ингредиенты найдутся в каждом доме.
Ароматные выпечки с ванилином по нраву взрослы и детям. Для комаров этот запах имеет противоположное действие. Кровососы теряют возможность учуять запах жертвы. Для защиты используется классический порошок ванилина. Чтобы приготовить средство от комаров, следует растворить 1 пакетик средства в 1 литре холодной воды. Полученную жидкость перелить в емкость с пульверизатором и обработать кожу и одежду.
Также готовят ванильный крем. Для этого необходимо взять любой детский мягкий крем и добавить в него ванилин. Ингредиенты тщательно перемешать и помазаться полученной субстанцией. Это безопасное и эффективное средство из ванилина может использоваться даже самыми маленькими детьми.
Еще один представитель мира пряностей, аромат которого надолго избавляет от кровососущих насекомых:
- Залить 200 воды 5 г высушенных бутонов гвоздики. Довести до кипения, проварить еще 15 минут. После этого отвар остудить и процедить. Полученную жидкость залить в пульверизатор и обработать одежду.
- Гвоздичную воду смешать с любым имеющимся одеколоном. Перед тем, как отправиться на природу, просто опрыскать на себя обновленными парфюмами.

Ароматерапия способна не только успокаивать и стимулировать, но и поможет спастись от комаров. Силу эфирных масел используют для защиты дома или на улице. Чтобы не кусали комары на природе, следует нанести по несколько капель на пульсирующие точки.
Эфирные масла от комаров оставляют жирные следы на одежде, поэтом следует очень аккуратно наносить их на тело.
Можно добавить эфирное масло в любой крем. Это несколько снизит его концентрацию и уменьшит риск развития аллергических реакций. Также можно воспользоваться бальзамом Звездочка, который применяется и для отпугивания насекомых и устранения последствий их укусов. Перед применением следует обязательно провести тест на чувствительность кожи.
Масла имеют очень высокую концентрацию и их не рекомендуется использовать людям со сверхчувствительной кожей.
Избавиться от комаров в помещении можно при помощи ароматической лампы. Достаточно добавить несколько капель любого из перечисленных масел. В результате в комнате будет витать легкий и приятный аромат, а комары постараются держаться подальше от этого места.
Сильный специфический запах нашатырного спирта способен обеспечить полноценный сон на всю ночь. Для этого смочить лоскут ткани в ингредиенте и обработать поверхности в доме. Особое внимание следует уделить подоконникам, оконным и дверным рамам.
Человек перестанет ощущать запах уже через несколько минут, а для насекомых это станет настоящей преградой на пути к жертве. Комары просто потеряют ориентир и не смогут добраться до нужного места. Аналогичным действием обладает и уксус в сочетании с шампунем.
Важно понимать, что народные средства от комаров действуют ровно столько, сколько будет ощутим их аромат на коже или одежде. Поэтому часто придется использовать их повторно, чтобы обновить защитные силы аромата.
Таким образом, знания того, что отпугивает комаров, поможет обеспечить защиту для всей семьи, не имея под рукой специальных средств от кровососущих насекомых. А безопасность указанных методов позволяет эффективно применять их даже для защиты маленьких детей.
Укус опасен тем, что в организм человека попадает инфекция. В результате развивается малярия – серьезное заболевание, которое в ряде случаев приводит к смертельному исходу.
Особую опасность для человека представляют те комары, которые ранее укусили больное животное.
Что происходит после укуса
Первый признак, свидетельствующий о том, что человека укусил комар – сильный, мучительный зуд. Затем пораженный участок кожи краснеет и отекает.
Обратите внимание! На первых порах установить, что человека укусило именно малярийное насекомое, невозможно.
Иная симптоматика
Когда ребенка или взрослого кусает малярийный москит, появляются следующие симптомы:
- судорожные сокращения мышц,
- ишемия головного мозга,
- специфические покалывания по всему телу,
- анемическое состояние,
- лихорадочное состояние,
- тошнота, переходящая во рвоту,
- боль в суставах,
- сильные головные боли,
- кровянистые примеси в моче.
Реакция после укуса может быть как общей, так и местной. Место укуса сильно воспаляется, отекает, болит. Характер боли – жгучий, мучительный. Болевой синдром, а также иная симптоматика, присутствуют в течение 2-3 часов, затем исчезают.
Какими могут быть последствия
Каждый год от последствий укуса паразита погибает до 1,6 миллиона человек. До 90% случаев инфицирования наблюдается в африканских странах.
В группе риска – женщины, вынашивающие плод, и дети до 5 лет. Их иммунитет ослаблен, и не может отразить атаку комара. Именно малыши и будущие мамы погибают от укусов чаще всего.
Как отличить неопасного комара от опасного
Если наблюдается вторичный случай, тогда врач устанавливает цепочку, и выявляет, откуда именно пошло это заражение.
Важно! Комар-долгоножка, которого на постсоветском пространстве боятся вплоть до фобических расстройств, не имеет никакого отношения к малярийным москитам.
Характерный облик этим комарам придают длинные ноги. Удлинены они за счет голени и лапок. Живут такие комары во влажных, или сильно увлажненных биотоках – в лесах, либо других древесных насаждениях.
Причиной болезни во время беременности является Plasmodium falciparum. Это возбудитель наиболее тяжелой формы патологии. Нередко молодая женщина гибнет.
Хроническая рецидивирующая форма малярии у будущих матерей провоцируется P.malariae, или P.vivax.
Болезнь протекает в очень тяжелой форме. В инкубационном периоде температура повышается до критических отметок. Иногда наблюдается атипичное протекание, и специфическая симптоматика отсутствует.
В 55% случаев развивается гиповитаминоз. Его появление способствует еще большему снижению защитных свойств организма.
Если атаковал комар, у беременной женщины могут наблюдаться такие тяжелые последствия, как эклампсия, или преждевременные роды.
При укусе обычно отсутствует наиболее яркий признак – пароксизм. Одновременно появляются следующие симптомы:
- судорожные сокращения мышц,
- диарея,
- боль в животе,
- тошнота (часто сопровождается отхождением рвотных масс).
На коже возникают специфические высыпания – геморрагия. Стремительно развивается анемия, что считается крайне опасным состоянием.
У детей после 6 лет и у подростков проявления малярии схожи с симптоматикой данной болезни у взрослых.
Как выглядит больной
Кожный покров при этом диагнозе отличается бледностью. На фоне поражения клеток печени и селезенки присутствует желтушность. При усилении потоотделения, кожа почти всегда очень влажная.
Человек выглядит истощенным, больным. Могут присутствовать мигренеподобные головные боли. Лихорадка сменяется ознобом. Такое состояние возникает периодически.
Что следует делать
Дальнейшее лечение осуществляется в условиях стационара. Оптимальный способ терапии – консервативное лечение.
О чем говорят специалисты
Лицам, перенесшим малярию, нужно наблюдаться у врача в течение 24 месяцев. Если периодически появляются признаки лихорадки, нужно сдать на анализ кровь. Возможно, потребуется прохождение дополнительного терапевтического курса.
Лицам, живущим в местах потенциальной угрозы, с приходом теплых дней нужно обязательно ставить на окна специальные сетки. Желательно каждый раз обрабатывать сетку любым инсектицидом.
Лицам, выбирающимся в поход, нужно подумать о защите рук и ног. Особенно это актуально вечером, ночью и ранним утром. Открытые части тела обрабатываются репеллентами.
Это связано с тем, что основной пищей для комаров является не человек, а крупный рогатый скот. Если падает численность прокормителей, то и популяция комаров также начинает стремительно снижаться.
Защититься от укусов можно при помощи средств индивидуальной защиты:
- спреев и аэрозолей,
- кремов и гелей,
- карандашей,
- специальных браслетов.
Средства индивидуальной защиты делают запах человеческого тела невкусным, непривлекательным для комаров. Такие препараты наносятся на кожу, либо на одежду.
По своему составу они могут быть химическими, или натуральными. В первом случае используются такие действующие вещества, как:
- пиретроиды,
- карбоксид,
- оксамат,
- ДЭТА.
В растительных препаратах присутствуют разнообразные эфирные масла, вытяжки, которые отпугивают насекомых.
Рекомендуется использовать препараты с высокой степенью защиты – они функционируют дольше 4 часов. Главный недостаток – высокая концентрация химических компонентов. Поэтому, при длительном использовании, такие средства могут существенно навредить здоровью человека.
Средства с низкой степени защиты разрешается использовать аллергикам, беременным и детям.
Важно! Если человек занимается активной трудовой деятельностью, время действия средства может быть ограничено.
В 80% случаев для защиты от комаров используются спреи. Они быстро и равномерно распределяются по коже. Главный минус – токсичность. У чувствительных людей может развиться аллергия.
Кремы и гели защищают от комаров в течение 8 часов. Преимущества – невысокая стоимость, эффективная защита, экономичность. Небольшого количества средства хватает для обработки обширных участков тела. Недостаток – есть риск испачкать одежду. Иногда остается ощущение липкости на теле. Если намочить обработанный участок, защитное свойство препарата утрачивается. Риск развития аллергии, в том числе и анафилактического шока, составляет 20%.
Комары очень боятся огня и дыма. Вечером желательно как можно больше времени проводить возле костра.
Заключение
Не стоит недооценивать опасность, которая исходит от комаров. Последствия могут быть катастрофическими.
Более подробную информацию об укусах и лечении возможных последствий можно узнать из видео в этой статье:
В сезон отпусков и частых поездок на природу каждый из нас сталкивается с проблемой надоедливых и не очень приятных насекомых. Зачастую страх вселяют пауки и незнакомые жуки, а на самом деле бояться нужно самого обычного комара, ведь именно он является переносчиком опасных инфекционных заболеваний.
Малярийный комар – не просто вредитель. Этот вид насекомого переносит одну из самых распространенных инфекций в мире – малярию. Ну а для убедительности в опасности дружбы (по своей воле или по воле случая) человека и малярийного комара следует привести сухую статистику: ежегодно от малярии по всему миру умирает в среднем от 1 до 3 миллионов человек. И несмотря на то что 85% случаев заражения происходит в странах Африки, риск подвергнуться атаке малярийного комара есть у каждого из нас.
На заметку! Важно знать, что сам по себе малярийный комар не представляет опасности. Ее таит в себе укус малярийного комара, который напился крови уже инфицированного человека. Так, будучи на курорте в африканских местностях, вы запросто можете стать жертвой зараженного насекомого, даже не подозревая о приближающейся беде.
Чем отличается малярийный комар от обычного?
Знать врага в лицо необходимо не только для общего развития, ведь если своевременно заметить опасное насекомое, то можно предпринять экстренные меры для предотвращения контакта с комаром и таким образом избежать укуса.
Вот чем отличается малярийный комар от обычного:
- Тело малярийного комара в два-три раза больше по размеру, чем у обычного насекомого (длина малярийного иногда достигает 3 см, в то время как комар-пискун обычно имеет размер около 7 мм).
- Длина ног малярийного комара заметно больше.
- Крылья малярийного комара покрыты темными пятнами.
- Сидя на сухой поверхности, обычный комар находится параллельно плоскости, в то время как малярийный комар высоко задирает заднюю часть туловища.
- Личинки также имеют отличия – личинки малярийного комара имеют сидячие дыхательные отверстия, в то время как личинка обычного комара на конце своего тельца имеет длинную дыхательную трубочку.
- Еще одно отличие личинок этих двух видов комаров – расположение на воде, противоположное расположение на сухой поверхности: малярийные личинки лежат на воде горизонтально, а вот личинки обычного комара располагаются под углом.
- Особенностью взрослой особи малярийного комара также является манера двигаться – непосредственно перед тем, как сесть на ваше тело, малярийный комар пританцовывает.
Чем опасен укус малярийного комара?
Если к укусам обычных комаров мы давно привыкли, и уже почти не обращаем на них внимания, то игнорирование укуса малярийного комара опасно для жизни.
Малярийный комар переносит заболевания:
- Малярия – проявляется мышечными болями, симптомами поражения нервной системы, приступами озноба, рвотами, температурой, головными болями.
- Желтая лихорадка – проявляется температурой, ознобом, резкими рвотой и тошнотой, поражениями сосудистой системы (кровотечения), а также головными болями с последующим нарастанием явлений желтухи.
- Лимфатический филяриатоз – это глистная инвазия человека или животного, приводящая к распространению паразитов по лимфатическим узлам и сосудам, приводящая к закупорке сосудов и тромбам. Вследствие этого лимфа накапливается в сосудах, органы тела раздуваются, начинают гнить, нередко вероятен летальный исход.
- Туляремия – сильная интоксикация, лихорадка, поражение лимфоузлов. Результат этого особо опасного заболевания – инвалидность и смерть зараженного человека.
Перечисленные инфекционные заболевания – далеко не все, чем способен порадовать малярийный комар. А чтобы не стать жертвой этого маленького, но опасного насекомого, запаситесь эффективными средствами защиты. Подробнее о некоторых из них рассказываем далее.
Как предотвратить укус малярийного комара – выбираем средство защиты?
Конечно же, если речь идет о жилище, то легче всего предупредить нашествие паразитов, чем пытаться бороться с ними. А какое средство — лучшая защита от комаров? Безусловно — противомоскитная сетка. Её основная функция – это защита от комаров, мошкары, грязи и пыли, а также пыльцы (что особенно актуально для аллергиков).
Современные москитные сетки различаются в зависимости от размера ячеек, прочности и вида материала, способов монтажа и функциональности.
Как выбрать сетку, которая нужна именно вам и на что обращать внимание при выборе, читайте здесь — выбор москитных сеток для дома.
Предназначение – борьба с кровососущими и паразитарными насекомыми как внутри помещения, так и на открытой местности. Шашка отличается острым инсектицидным действием, в короткое время выделяя большое количество активного вещества перметрина. Шашка эффективна для обработки 1000 м 3 закрытой территории и 300 м 2 открытого пространства, время действия – до 14 суток.
Малотоксичная для домашних животных и людей, помощь профессионала для работы с шашкой не требуется. Уничтожает комаров, мух, слепней, клопов, блох, муравьев, тараканов и мошку.
Средняя цена в России – около 450-480 рублей.
Браслет от комаров BUGSLOCK
Предназначение – отпугивание назойливых насекомых. Срок работы – до 10 дней непрерывно. Хранится браслет в коробочке, которая помогает сохранить свойства мобильного репеллента. Нечастое использование браслета, например, выезды на природу всего раз в неделю, позволяет средству работать для вашей безопасности все лето!
Ремешок пропитан натуральными маслами лаванды и цитронеллы, что будет весомым аргументом для мам – такие браслеты абсолютно безопасны для детей (малышам в возрасте до 5 лет носить браслет лучше на лодыжке).
Средняя цена в России – около 110-129 рублей.
Лосьон UltraThon
Укус малярийного комара вам не грозит, если тело обработано этим средством. Предназначение лосьона – отпугивание комаров, мошки и клещей. Время действия – до 12 часов благодаря стабильности формулы.
Эмульсия эффективно работает при различных уровнях влажности окружающей среды, а также способна защищать вас от опасных насекомых в разных температурных режимах.
Средняя цена в России – около 500-520 рублей.
Когда вы отдыхаете на природе или работаете на даче, вам некогда присматриваться к насекомым и разбираться, какой комар малярийный, а какой похож на обычного комара. Комфортный отдых или плодотворная работа должны быть безопасными в любых условиях. И если выезжая на пикник мы всегда помним о том, что при себе необходимо иметь средства защиты от комаров, то в дачный сезон просто некогда думать об этом, а считать по инструкции 10 дней с момента первого нанесения репеллента – и подавно.
На помощь в таких случаях придет уничтожитель комаров для дачи SkeeterVac, помогающий не просто отпугнуть, а и полностью подавить размножение и вывести насекомых с вашей территории.
Инновационная установка выделяет тепло вместе с углекислым газом, имитируя тем самым дыхание человека. Это привлекает преступников – в поисках очередной жертвы комары слетаются на установку, и уже не возвращаются в места своего обитания: вентилятор попросту всасывает целые армии насекомых в свой контейнер, предназначенный для сбора вредителей.
Серьезный результат работы устройства будет заметен уже через 3 недели – на территории до 45 соток и вовсе не останется особей, которые могут дальше представлять опасность для человека и тем более размножаться.
Средняя цена системы в России – около 38 500 — 40 000 рублей.
Малярийный комар не должен приводить вас в ужас при одном только виде. Представленная информация поможет вам отличить малярийного комара от обычного насекомого и вовремя предпринять меры по защите членов своей семьи от потенциально опасного крылатого.
С весной, когда солнышко греет уже достаточно сильно, просыпаются первые комары. И с их появлением жизнь человека превращается в кошмар. Бесконечный писк, множество укусов вызывающих аллергическую реакцию – это еще не все последствия появления кровопийц. Проблема избавления от кровожадных тварей волнует как городских, так и деревенских жителей. Как правило, преследуя цель спастись от комаров, многие используют репелленты. Но не всегда их использование оправдано, все-таки это химические средства, которые иногда нежелательно или вообще невозможно использовать. Тогда борьба с комарами с помощью народных средств становится единственным выходом.
Как выглядит и что представляет собой комар
Комары относятся к семейству двукрылых насекомых к разряду кровососущих комаров. Размеры взрослых особей могут быть от 3 мм до 5 см, в зависимости от вида. Цвет тельца также варьируется. Чаще всего встречаются особи с черным или серым окрасом, но могут быть виды с тельцем оранжевого, красного, желтого или зеленого цветов. Хотя насекомые относятся к семейству двукрылых насекомых, на самом деле у них две пары крыльев, одна из которых утратила свои функции.
Относятся к насекомым, для которых характерно полное превращение. Комары проходят четыре стадии развития: яйцо – личинка – куколка – взрослая особь. Первые три стадии проходят в водоемах, на поверхность попадают только взрослые особи.
Вид спаривания этих летающих насекомых называется эвригамия, то есть самцы сбиваются в рой и поджидают самок, чтобы оплодотворить их. Самки привлекают самцов жужжанием, похожим на писк, которое создается при движении крыльев. Самка влетает в рой и ее оплодотворяет самец. После спаривания самец возвращается в рой, а самка улетает в поисках крови, необходимой для вынашивания потомства. Примечательно, что в городских условиях распространен вид спаривания стеногамия, то есть по одиночке, поскольку в городе нет такого количество открытого пространства, и образовать рой в таких условиях затруднительно.
Количество яиц в кладке прямо зависит от количества выпитой крови, поэтому насекомые так агрессивны по отношению к человеку. В одной кладке самка может отложить от 30 до 150 яиц. Яйца откладываются на поверхности водоема в спокойной стоячей воде с минимальной скоростью течения., например в лужах, прудах, озерах, в зарослях камышей.
В течение 20 дней личинка линяет 4 раза, сбрасывая старую тесную шкурку, и постепенно увеличиваясь в размерах. Так, за это время размеры тела личинки могут увеличиться в 500 раз. После последней линьки личинка превращается в куколку. Куколка тоже обитает в водоеме, периодически всплывая на поверхность за кислородом. Куколка по образу жизни идентична личинке.
Спустя 5 дней из личинки появляется взрослая особь, которая перебирается жить на сушу. Продолжительность жизни самцов составляет около 3-х недель, в то время, как у самок – около 3-х месяцев, однако при неблагоприятных условиях жизнь вредителей становится более короткой.
Благоприятные условия для проживания и размножения вредителей – теплая погода (более 16 градусов) и высокая влажность (более 80%). Однако комары быстро адаптируются и к неблагоприятным для них условиям. В умеренном климате насекомые активны с мая по октябрь. В летнее время в природе комары часто обитают недалеко от прудов, озер, болот и других мест с повышенной влажностью.
Зимой же переселяются в теплые хлева, где живут домашние животные. В городских условиях они живут в подвалах или канализациях. При температуре воздуха меньше 16 градусов комары впадают в зимний анабиоз. Таким образом продолжительность жизни самок может продлеваться до года.
Многие виды комаров безвредны для человека, поскольку питаются нектаром растений. Но самки часто питаются еще кровью, которая нужна для вынашивания потомства, поэтому кровопийцы поселяются рядом с человеком. Жертву кровопийцы чувствуют с помощью усиков за много метров.
Опасность комаров для человека
Комаров нельзя назвать безвредными насекомыми, так как при благоприятных условиях они могут являться переносчиками различных заболеваний – туляремия, желтая лихорадка, гельминтоз, гепатит В и С, болезнь Лайма и другие. К счастью, в наших широтах такие комары не переносят такие инфекции. Но кроме этого, во время укуса комар запускает в ранку слюну, которая не дает крови сворачиваться. Эта слюна нередко вызывает аллергическую реакцию. В местах укуса как правило появляется отек и зуд. У людей, страдающих астмой, могут появиться приступы удушья.
У некоторых людей проявляется комариная аллергия, которая сопровождается повышением температуры, головной болью, затруднением дыхания, сильным отеком, на месте укусов появляются волдыри. При многочисленных укусах возможно появление удушья, отека Квинке, тошноты и рвоты. Известны случаи, когда у человека наступал анафилактический шок.
Во время путешествий в экзотические страны укус комара может привести к печальным последствиям. Иногда люди становятся переносчиками инфекционных заболеваний, сами того не зная. Опасность укусов тропических видов заключается в том, что человек не обращает вовремя внимание на укусы, болезни могут проявляться не сразу (инкубационный период некоторых заболеваний составляет до полугода), врачам сложно диагностировать заболевания, нехарактерные для данной местности.
Народные рецепты против комаров
Когда в доме есть дети или взрослые, чувствительные к химии, встает вопрос – как спастись от комаров без применения химических препаратов. Тогда на помощью приходят разные народные хитрости. Давайте же разберем, чего боятся комары и как от них избавиться.
Ни для кого не секрет, что существуют растения, которые своим запахом отпугивают вредителей. Это знание активно используют садоводы и огородники против насекомых на участке, но и мы с вами может прибегнуть к такому методу, чтобы отпугнуть кровососов.
- Цитронелла. Экстракт цитронеллы часто используют в репеллентах. Яркий аромат растения не дает кровопийцам учуять запах человека. Отлично растет как на подоконнике в квартире, так и в открытом грунте. В нашем климате цитронелла растет один год, поэтому неплохо растение высаживать в горшки, а на зиму убирать в тепло. Бонусом идет то, что растение потом можно использовать как приправу на кухне.
- Розмарин. Как все знают, это отличная приправа на кухне. Но розмарин еще и гнусов отпугивает, и бабочек привлекает на участок. Обладает полезными для организма человека свойствами: нормализует состояние жирной кожи, способствует развитию мозговой активности, улучшает память.
- Бархатцы. Часто появляются на наших клумбах. Своим резким запахом отпугивают многих насекомых – тлю, белых мошек, комаров и прочих. Неприхотливы в уходе, можно высаживать на клумбах в открытом грунте и в горшках на балконе.
- Базилик. Еще одна отличная приправа. Можно сажать на грядках в огороде или в контейнерах в квартире. За счет многообразия сортов базилик является украшением подоконника или огорода: с помощью растений разного цвета можно создавать красивые композиции.
- Лаванда. Лучше высаживать в горшки или контейнеры и летом просто выносить на улицу, так как растение плохо переносит холода. Высушенные цветы лаванды можно использовать в выпечке или заваривать чай, также она является отличным антисептиком, помогает наладить здоровый сон. Саше из высушенных цветков лаванды помогут сберечь вещи от моли.
- Котовник или кошачья мята. Цветы котовника внешне похожи на лаванду. Эфирные масла в соцветиях, которые отпугивают комаров и мух, привлекают кошек, из-за чего кошки очень любят это растение.
- Пижма. Растет в глинистой почве. Помогает отпугивать не только комаров, но и мух, и клещей. Но запах этого растения заставляет насекомых перемещаться на небольшое расстояние, поэтому пижму нужно высаживать по всему огороду, либо высадить в том месте, где вы чаще всего проводите время.
- Герань. Частый гость на подоконниках. Неприхотлива в уходе и радует своими красивыми цветами. Высаживать можно не только в горшках в квартире, но и на клумбах. Разнообразие сортов и видов герани поможет создать необычный ландшафтный дизайн.
- Болотная мята. Этот вид мяты дает очень сильный аромат. Высаживать лучше в открытом грунте, поскольку запах у растения очень резкий для выращивания его в помещении.
- Полынь. Горькая трава, из которой часто делают лечебные настои и мази. Отлично помогает от большинства насекомых в доме, если разложить высушенные пучки по углам квартиры. На участке помогает против москитов и прочих насекомых.
- Бузина. Высаживать кусты можно в огороде, но необходимо следить, чтобы растение сильно не разрасталось. Букет из цветов бузины украсит ваш дом, а ягоды можно использовать в лечебных целях.
- Мелисса. Простая и неприхотливая в уходе. Из веточек и листьев получается ароматный чай, который успокаивает и способствует нормализации сна. Высаженная на грядке мелисса отпугивает москитов на улице, а если натереться настоем из мелиссы, то комары даже не сядут на кожу.
Эфирные масла тоже могут помочь избавиться от комаров в квартире или в доме. Их можно использовать в аромалампах, можно разводить в воде и опрыскивать помещения в доме или наносить на кожу. Но нужно быть аккуратным, масла нельзя наносить в чистом виде, так как они очень концентрированные и некоторые из них могут вызвать раздражение на коже.
- Цитронелла. Аромат похож на лимон, а запах цитрусовых хорошо отпугивает гнуса.
- Эвкалипт. Мало эвкалипта широко используется для ингаляций при лечении простудных инфекций. В составе масла более 40 разных соединений, что позволяет отпугивать не только гнусов, но и других насекомых.
- Герань. Один из вариантов использования аромата герани. В средствах от комаров используют эфирное масло герани в паре с маслом цитронеллы.
- Чайное дерево. Применение этого масла очень распространено, например в косметологии. Но аромат чайного дерева еще и прекрасный репеллент.
- Гвоздика. Масло получают из бутонов и из листьев. Масло из бутонов более концентрированное и хуже воспринимается человеческим носом, но зато и эффект от него лучше.
- Ваниль. Широко используется в парфюмерии, а также в кулинарии.
- Бергамот. Еще одно цитрусовое эфирное масло, которое также отлично работает.
Кроме тех пряных трав, о которых мы уже рассказали, помогут спастись от комаров и такие пряности и приправы:
- Чеснок. Соединения серы в чесноке дают запах, которые отпугивает москитов и других насекомых в доме. Можно высаживать в горшке или на грядке, а можно использовать свежие или высушенные головки чеснока.
- Гвоздика. Нужно сжечь несколько семян гвоздики, запах отпугнет кровососов. Еще вариант – разложить семена гвоздики по дому и у входа в дом. Можно воткнуть семена в разрезанный пополам лимон и поставить его возле кровати, тогда москиты не будут беспокоить ночью.
- Корица. Порошок корицы нужно развести в теплой воде и расставить емкости с этим раствором по дому.
- Черный перец. Поджарьте несколько горошков черного перца и разложите по всему дому. Запах жженого черного перца невыносим для кровососов.
- Лавровый лист. Измельчить лавровые листья и разложить по разным комнатам. Многие насекомые, в том числе и мухи, не переносят этот запах.
- Эвкалипт. Листья эвкалипта обладают сильным ароматом. Чтобы отпугнуть москитов, можно использовать два способа: сжечь листья и разложить в помещении, или можно сделать настой из листьев и емкости с настоем также расставить по всему дому.